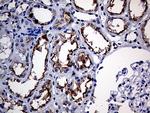
APBB1IP Antibody in Immunohistochemistry (Paraffin) (IHC (P))

Search
OriGene
APBB1IP Monoclonal Antibody (OTI6E3), TrueMAB™
{{$productOrderCtrl.translations['antibody.pdp.commerceCard.promotion.promotions']}}
{{$productOrderCtrl.translations['antibody.pdp.commerceCard.promotion.viewpromo']}}
{{$productOrderCtrl.translations['antibody.pdp.commerceCard.promotion.promocode']}}: {{promo.promoCode}} {{promo.promoTitle}} {{promo.promoDescription}}. {{$productOrderCtrl.translations['antibody.pdp.commerceCard.promotion.learnmore']}}
图: 1 / 4
APBB1IP Antibody (TA809230) in IHC (P)

产品信息
TA809230
种属反应
宿主/亚型
分类
类型
克隆号
抗原
偶联物
形式
浓度
规格
纯化类型
保存液
内含物
保存条件
运输条件
靶标信息
RIAM appears to function in the signal transduction from Ras activation to actin cytoskeletal remodeling. Suppresses insulin-induced promoter activities through AP1 and SRE. Mediates Rap1-induced adhesion.
仅用于科研。不用于诊断过程。未经明确授权不得转售。
篇参考文献 (0)
生物信息学
蛋白别名: Amyloid beta A4 precursor protein-binding family B member 1-interacting protein; APBB1-interacting protein 1; MLLT10/APBB1IP reciprocal fusion; MLLT10/APBB1IP reciprocal fusion protein; PREL-1; proline rich EVH1 ligand 1; Proline-rich EVH1 ligand 1; Proline-rich protein 73; Rap1-GTP-interacting adapter molecule; Rap1-GTP-interacting adaptor molecule; Rap1-interacting adaptor molecule; RARP-1; Retinoic acid-responsive proline-rich protein 1; RIAM; RIAMRARP-1; unnamed protein product
基因别名: APBB1IP; INAG1; PREL1; RARP1; RIAM
UniProt ID: (Human) Q7Z5R6
Entrez Gene ID: (Human) 54518




